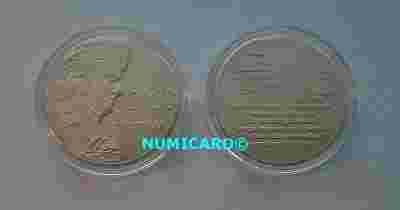

2000 FRYDERYKÓW -(RANT GŁADKI) TOMBAK NumiC
Aukcja w czasie sprawdzania nie była zakończona.
Cena kup teraz: 11 zł
Użytkownik NUMI-CARD
numer aukcji: 2072881437
Miejscowość Kietrz
Zostało sztuk: 2
Wyświetleń: 5
Koniec: 27-01-2012, 11:02
